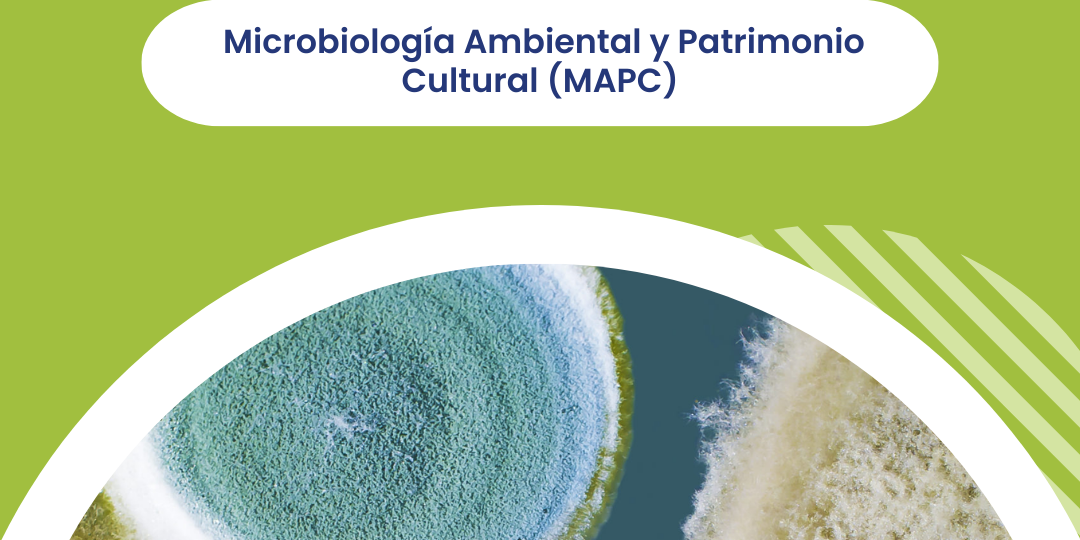
4

Noticias
El enfoque del VII Congreso del GE-IIC, Conservar lo material para desvelar lo inmaterial. Función social de la conservación del…
El hierro y las aleaciones de cobre son parte del grupo de metales más comunes en yacimientos arqueológicos subacuáticos. La…